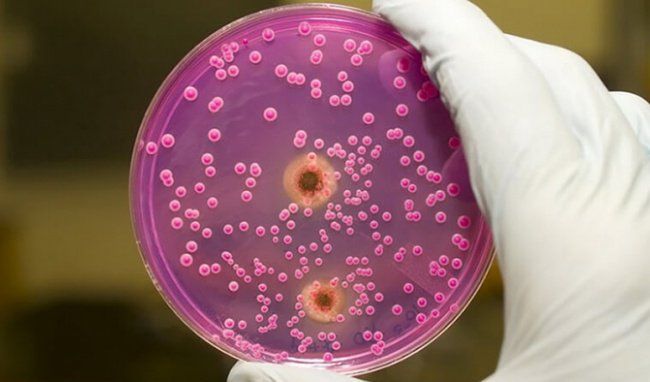
Ý nghĩa xét nghiệm Mycoplasma hominis PCR

Ý nghĩa xét nghiệm Mycoplasma hominis PCR


1. Vi khuẩn Mycoplasma hominis là gì?
Mycoplasma hominis là nhóm vi khuẩn thường được tìm thấy trong niêm mạc miệng, họng và đường sinh dục ở cả nam và nữ giới. Tình trạng nhiễm khuẩn sẽ xuất hiện nếu lượng vi khuẩn này trong cơ thể tăng lên. Khác với các vi khuẩn thông thường, mycoplasma hominis là loại chỉ quan sát được trên kính hiển vi nền đen hay kính hiển vi điện tử.
Vi khuẩn Mycoplasma hominis có thể cư trú ở nhiều vị trí trên cơ thể và gây ra các bệnh cảnh khác nhau, bao gồm: Viêm phổi hay bệnh lây qua đường tình dục ở cả nam và nữ giới...Đối với phụ nữ có thai, Mycoplasma hominis có thể gây viêm khung chậu và dẫn đến sảy thai. Đặc biệt, nếu thai phụ bị nhiễm trùng sinh dục bởi loài vi khuẩn này thì khi sinh ra, trẻ có thể bị nhiễm trùng máu hoặc viêm màng não...
Để chẩn đoán nguyên nhân gây ra các bệnh do vi khuẩn mycoplasma hominis, bác sĩ thường chỉ định cho bệnh nhân làm xét nghiệm Mycoplasma hominis PCR từ mẫu bệnh phẩm là dịch họng, mủ, huyết thanh.
2. Xét nghiệm Mycoplasma hominis PCR
Xét nghiệm Mycoplasma hominis PCR được chỉ định để phát hiện sự tồn tại DNA của Mycoplasma hominis ở trong mẫu bệnh phẩm. Người thực hiện xét nghiệm và đọc kết quả phải là những nhân viên đã được đào tạo và có chứng chỉ hoặc chứng nhận về chuyên ngành vi sinh.
Xét nghiệm Mycoplasma hominis PCR nhằm xác định chủng Mycoplasma hominis bằng phương pháp PCR được đánh giá là một trong những kỹ thuật có độ nhạy và độ đặc hiệu cao, rất được khuyến khích sử dụng ở các cơ sở y tế chuyên sâu để chẩn đoán các bệnh lý về viêm nhiễm đường sinh dục.
Mẫu bệnh phẩm dùng trong xét nghiệm Mycoplasma hominis PCR có thể là dịch cổ tử cung, dịch niệu đạo,...của người có nghi ngờ có căn nguyên do Mycoplasma hominis gây bệnh.
Mẫu bệnh phẩm của người bệnh sẽ có phản ứng dương tính khi có sản phẩm PCR là một băng đặc hiệu duy nhất, rõ nét, không bị đứt gãy. Mẫu bệnh phẩm có phản ứng âm tính nếu không có vạch sản phẩm PCR với kích thước tương ứng với đoạn gen đích cần khuếch đại.
Nếu kết quả xét nghiệm Mycoplasma hominis PCR cho phản ứng dương tính giả thì có thể do tập nhiễm của môi trường gây ra. Nếu mẫu bệnh phẩm cho cho kết quả âm tính giả thì có thể là do phản ứng PCR bị ức chế.
Tóm lại, nếu muốn có được kết quả chính xác thì người bệnh cần đến cơ sở y tế uy tín với hệ thống trang thiết bị hiện đại để tiến hành xét nghiệm Mycoplasma hominis PCR.

Ho rát họng có đờm là một vấn đề phổ biến có thể gặp ở bất kỳ ai. Nguyên nhân của tình trạng này có thể là viêm amidan, cảm cúm, viêm họng, thậm chí là ung thư vòm họng.
![[Góc giải đáp] Viêm Phế Quản Có Lây Không?](/uploads/suc-khoe/2023_12/viem-phe-quan-co-lay-khong.png&w=250&h=250&checkress=dccabc90558be2a987edc1d415786e89)
Viêm phế quản là một bệnh lý phổ biến trong xã hội ngày nay mà nhiều người có thể mắc phải. Tuy viêm phế quản không gây nguy hiểm đến tính mạng nhưng có thể ảnh hưởng đáng kể đến sức khỏe của người bệnh.

Ho, sốt đau họng là những triệu chứng thường gặp cùng lúc và có thể ảnh hưởng đến cuộc sống hàng ngày. Bài viết dưới đây sẽ làm rõ nguyên nhân, cách nhận biết và những phương pháp hiệu quả để giảm nhẹ và xua tan những triệu chứng này.

Là một phần quan trọng của hệ hô hấp, họng thường mắc phải nhiều bệnh lý khác nhau. Các bệnh về họng có thể đơn giản chỉ là viêm họng hoặc có thể nghiêm trọng hơn như viêm amidan, viêm thanh quản và thậm chí ung thư họng.

Thời điểm giao mùa, các trung tâm Y tế đang ghi nhận nhiều trường hợp bệnh nhi mắc viêm phổi do vi khuẩn Mycoplasma. Đây là một bệnh thường xuất hiện trong mùa giao mùa, đặc biệt làm lây lan nhanh chóng.

Ferritin là một loại protein dự trữ sắt và giải phóng sắt khi cơ thể cần. Ferritin tập trung chủ yếu trong các tế bào và chỉ có một lượng rất nhỏ lưu thông trong máu.

Xét nghiệm sắt huyết thanh giúp phát hiện nồng độ sắt trong máu thấp hoặc cao hơn bình thường.














